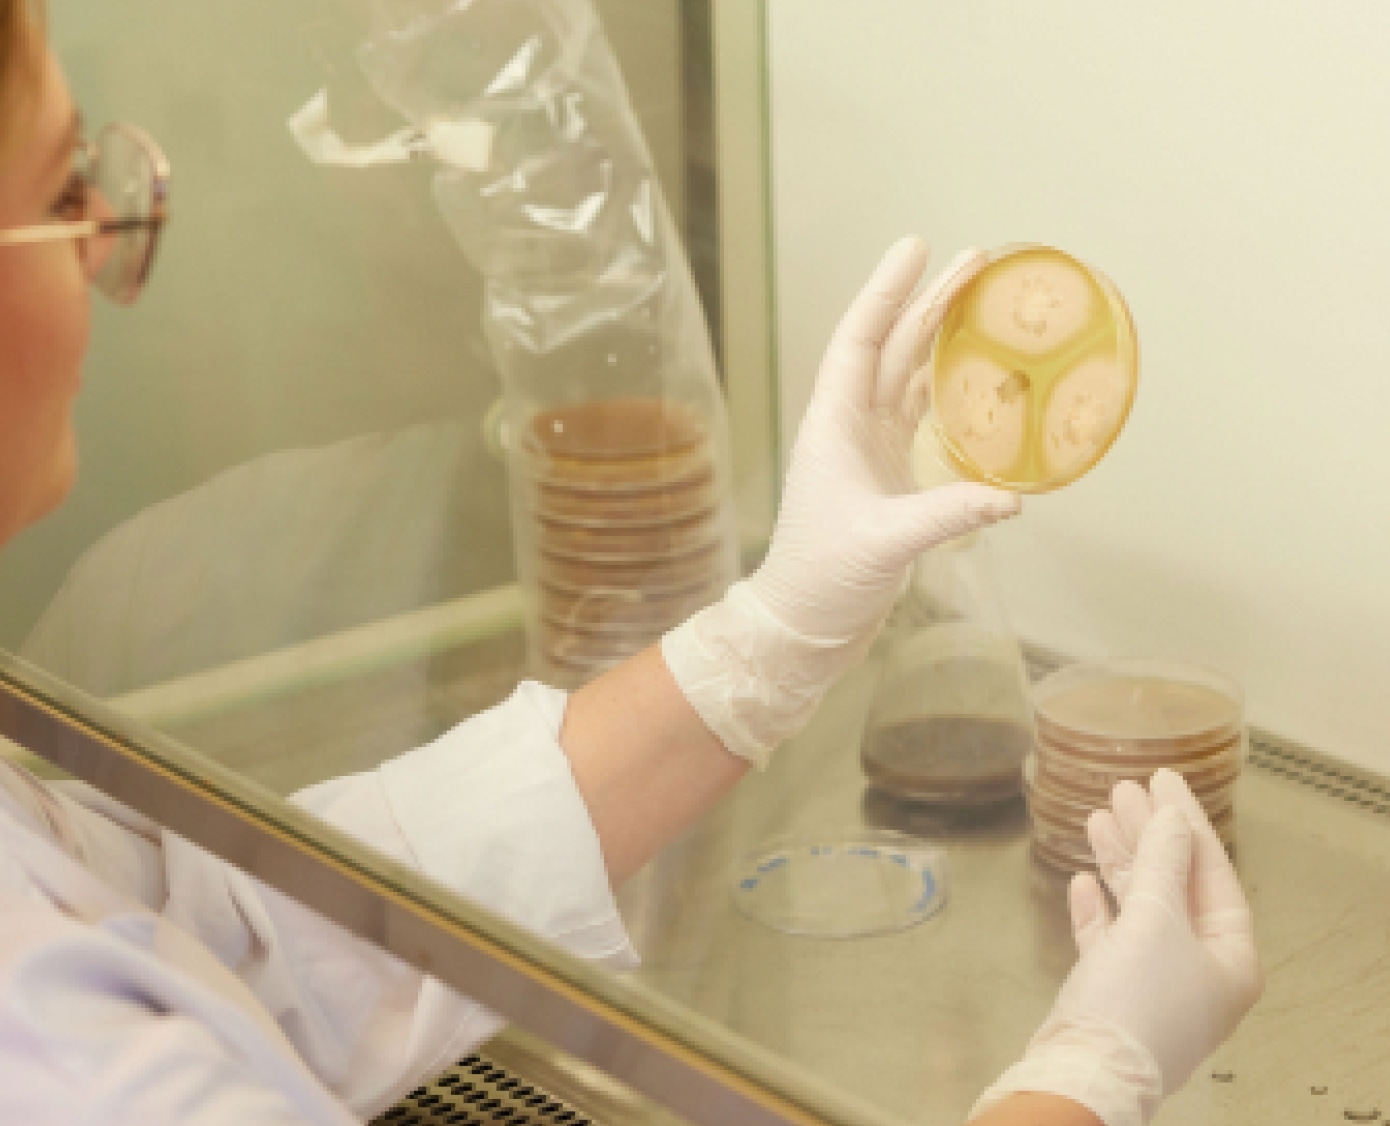

Fungi
Force
Frans van Rooijen en Michael Sailer
Entrepreneur Frans van Rooijen and scientist Dr. Michael Sailer are launching a varnish made from natural raw materials. Harmless fungi, together with linseed oil, form a natural protective layer against sun and water. The bio finish can repair itself when damaged via an organic process and is fully circular when it’s absorbed back into nature.
Wood is a beautiful natural product, but once cut it needs protection against weather conditions. We paint, varnish or impregnate wood to make it weather-proof, but these products mainly consist of chemicals. As a result, the wood cannot be recycled, and toxic substances end up in our natural environment.
We spoke to Frans about his frustration at how humans destroy beautiful natural products, and how he wants to change this.


Photography: Anouk Moerman
Film: Blickfänger
Hi Frans, what drives you as a person, and what problem are you trying to tackle?
To be honest, I was never concerned with circularity much when I was younger. Until 25 years ago when I became the director of a company involved in water purification. There I learned how we deal with water in this world, which did not make me happy. I learned that a cotton T-shirt takes 4,000 litres of water to produce, and a steak 50 bathtubs full. I read about the volumes of pesticides ending up in our water supplies. As a human society, we are polluting and abusing our water at a rapid pace.
The more I learned, the more I wanted our company to have a positive impact. That turned out a little differently, because in the meantime a private equity fund had bought into the company. They didn't really care for my mission, they just wanted 30% growth. When I indicated this was not possible, there was not much room for conversation. Long story short: I was out the door pretty quickly.
You stuck to your principles. What did you do next?
I studied Industrial Engineering and Mechanical Engineering and love developing and experimenting. Once I realized the state the Earth is in because of human actions, I couldn't go back, and I wanted to do something meaningful. I ended up in the timber sector because I think wood is a very beautiful material. It’s circular and one of the few raw materials that is not finite. It absorbs CO2 and always grows back. But I also discovered that how we deal with wood is miserable. People choose to destroy this beautiful product with toxins.
Once I realized the state the Earth is in because of human actions, I couldn't go back, and I wanted to do something meaningful.
What does the world of wood look like and how can it be improved?
I was then working as the director of a company that imported FSC-certified wood from Africa. That seemed like a good thing on the surface, but I was really shocked by the world of timber traders. It turned out that no one was concerned with delivering a good, sustainable product. Every penny was pinched and the FSC rules were blurred and fiddled with constantly. I also discovered that the wood industry uses a lot of chemical coatings that are toxic for humans and nature alike. Wood is a beautiful product, but once cut it needs protection against the weather. Without weatherproofing, the wood will become damp, and mould will grow and eat the wood. To prevent this, we paint, varnish, or impregnate the wood. But this is always nasty, chemical stuff that ends up destroying a beautiful natural product.
How did you then go about ensuring that wood remains a beautiful natural product? What solution did you develop?
I met Dr. Michael Sailer, a German scientist who worked for TNO after his PhD research. He discovered that a naturally occurring and completely harmless fungus - called Aureobasidium Pullulans – can also protect wood. The fungus attaches to the wood surface, forming a permanent protective layer against sunlight. And in this way, it repels any other harmful fungi from the wood. Sailer looked for companies that were interested in further developing this application and bringing it to market. I thought it was a great story and saw opportunities to develop a sustainable alternative to the existing chemical supply of coatings and varnishes. To really make a difference.


You wanted to bring a sustainable alternative to the market where mould does not attack the wood, but instead provides protection?
Precisely! Nowadays we prefer to talk about 'bio coating', because people can’t wrap their head around mould as a solution. But indeed, that bio coating contains a surface fungus that doesn’t need the wood to live on. The fungus can also withstand the sun very well: it produces black-coloured cells to protect itself against UV, just like people who live their lives under the bright sun. That is why our varnish is black. It’s a living coating that must be 'fed' with some regularity.
That “food” is the second part of our bio coating. This fungus feeds on linseed oil. Linseed oil is made from flax, which is produced locally. The fact that linseed oil is a good natural material is not new, people knew that 300 years ago. But it also turns out to be an ideal breeding ground for our fungus. Without linseed oil, our mould would wash right off the wood surface. And without mould, the linseed oil would harden and no longer protect the wood against moisture. But together they form a perfect bio coating that protects the wood and allows it to breathe thanks to a natural process.
In a way you are imitating nature, in a jar. Is that the strength of your product compared to what else is out there? What is your product’s most important quality?
All the current solutions available to protect timber and wood products are designed to stop nature. By coating it with chemicals, nature cannot get a hold of the wood and it lasts longer. We see this as a battle that you fight, but which you always lose in the end. Because those chemicals in paints and varnishes always end up in the environment, which is terrible for nature and for humans alike. We choose to use a system that exists in nature and can continue to exist. By using this system, nature itself can do the work and we don’t cause unnecessary harm. Makes perfect sense.
I was very disappointed by how difficult it is to bring a sustainable innovation to the market.
You help to protect wood using a natural process. How did you bring this to market? Is it already a commercially viable product?
We are now on the market and our product is available for sale. But that didn't happen without a fight. The regulations in our country make it difficult to develop sustainable alternatives. When you develop a product like ours, at some stage you run into the Crop Protection and Biocide Admission Board (CTGB). This institution was devised to protect consumers against dangerous products. But in my experience, they - unintentionally – end up protecting the existing industry against newcomers.
Take Roundup for example, a weed killer known to be a terrible poison that kills just about everything it meets. Terrible for the environment, and still this product has been allowed back on the market. While we get bogged down in an impossible maze of rules and regulations, we were busy bringing a fully circular and natural product to the market!
New products first have to be submitted to extensive testing. The test program lasts 4 to 5 years and costs a few million euros – not exactly feasible for a small entrepreneur. That’s how the biggest companies, helped by government regulations, hold back all kinds of innovations. I was very disappointed by how difficult it is to bring a sustainable innovation to the market. But fortunately, we came to an agreement with the CTGB. We now have Xyhlo as a brand, which is our B2B branch. And we sell the bio coating to consumers under the name Fungi Force.
Offering our customers ready to go, sustainably treated planks, makes it easier to choose our product.
Today you have an environmentally friendly product for both consumers and the business market. You already mentioned some challenges that you have been able to overcome. What are the biggest dilemmas you currently face?
We started our B2B arm first and we quickly learned that we weren’t just selling a new product, but also promoting a change in behaviour. Contractors and builders don’t embrace innovation, they prefer to keep doing what they have always done. That way they know what to expect.
Look, our product must attach itself to the wood of its own accord. And that takes a while. If you use a traditional varnish, it contains a chemical to help it attach and dry quickly. That makes it nice and easy to use. With a bio coating this
works differently, and you must wait longer for it to dry. You also must take the weather into account, because if it rains heavily and the coating has not yet dried properly, there is a risk it will wash off. Ideally the coating takes place somewhere sheltered. In that way our product requires a different way of working.
The construction world is not that dynamic, and the readiness to adapt to a new way of working turned out to be a much bigger hurdle than I had anticipated. So, in addition to the bio coating for consumers, we decided to expand our B2B range with fully varnished planks. We have developed a new production line where we varnish planks and then dry them in the factory with UV. Offering our customers ready to go, sustainably treated planks, it makes it easier to choose our product.
Looking back, I started off with a bang, acting from a green heart. Only, I presented the solution too theoretically and people did not find fungi an attractive story. Over time, I realized that my potential customer base needed time to adjust their mindset and absorb what we were offering.


Your circular solution requires a change in behaviour. It doesn't seem like rocket science, but it turns out people have a hard time changing their mindset and their habits. How do you deal with that?
We are quite principled, because we know that the existing supply of wood treatments is destroying the planet. Our mission is to do make a real contribution to solving this problem. An example is our choice of linseed oil. There are all sorts available, including a quick-drying linseed oil. That would make it easier for everyone, because then you would no longer have to deal with the long drying time. But quick-drying linseed oil is full of so-called additives, heavy metals and is very bad for the environment. We have stuck to our principles on this and only use regular, natural linseed oil in our product. The result is that the drying time is longer, and we therefore must educate our customers to work in a different way.
And yes, all this has been disappointing at times. It is very difficult to innovate in a conservative market. For example, I was once visiting a paint manufacturer and he said to me: “I think it's a wonderful product, but we do EVERYTHING we can to keep mould out. They ruin our product and machines, so we’ll never go for this.” The system, the factory process, is organized in such a way that it supports chemical processing and sees natural processes as the enemy. It's a battle with a slow, outdated industry. We try to make our story and product integrate into the existing system, but convincing these parties takes a lot of time.
Your journey has had some twists and turns and you’ve come a long way! How do you see the future and what will it take to get there?
Our ambition is to make the product a success and spread the word far and wide. I don't necessarily have the desire to operate a large company or factory myself and have always been a big supporter of local production. This fungus is found almost all over the world. I am keen to teach others how to produce this bio coating and start to sell licenses. I am now working on setting up that system properly. My ambition is to distribute a great product around the world.
What we need now is our first manufacturer who is brave enough to start manufacturing with fungi. We want to use existing infrastructure, there are plenty of locations where they can set up a separate production space to pioneer this alongside their other traditional manufacturing processes. This is how we can get to scale and impact the fastest. So, paint manufacturers, we‘re ready, who dares to be the first?
We must start using wood in a truly circular way. There’s no time to waste.
Finally, what is your main message to the manufacturers and to all of us?
With this product I want to contribute to a better world, and I want to spread that message globally. In that regard I'm working on my brand awareness and grabbing every opportunity that comes my way. There is no doubt that humanity must start treating with our planet and its resources in a completely different manner. We must start using wood in a truly circular way. There’s no time to waste!
Facebook: facebook.com/xyhlo